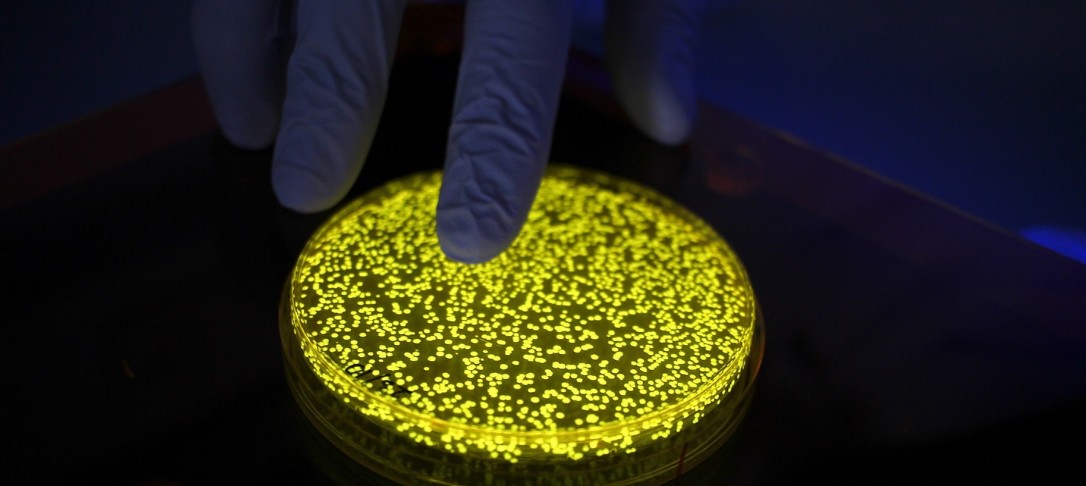

As part of our Bioeng COVID-19 Virtual Seminars series, join us for a research talk by Professor Tom Ellis on yeast and how it’s being used in the research and development of a vaccine against Coronavirus.
_____
Abstract:
Lots of people have taken to home baking during the pandemic, but did you know that the vital ingredient yeast is also busy helping us make a vaccine? Yeast doesn’t just help us make beer, bread and champagne but it is also is a key organism in biotechnology and one of the top cells for bioengineering by synthetic biology. Yeast synthetic biology is being used around the world to find drugs that block SARS-CoV2 and to investigate potential mutations it could acquire. But in the Bioengineering Department at Imperial College London, we are using engineered yeasts to help manufacture a promising candidate vaccine against this virus. In this talk, I’ll explain how yeast synthetic biology can help scale the manufacturing of a virus-like particle (VLP) vaccine. A vaccine that thanks to its yeasty-roots, may one day even be produced by breweries.
Biography:
 Tom Ellis FRSC is a Professor in the Bioengineering Department of Imperial College London. Tom joined Imperial as a group leader in 2010 to help establish research at the UK’s first centre for synthetic biology. Prof Ellis is now leading the UK’s effort in the world’s largest synthetic biology project, the Synthetic Yeast Genome (Sc2.0) Project and is Associate Faculty for Synthetic Genomics at the Wellcome Trust Sanger Institute. He is not very good at either home baking or home brewing, but can at least understand DNA quite well.
Tom Ellis FRSC is a Professor in the Bioengineering Department of Imperial College London. Tom joined Imperial as a group leader in 2010 to help establish research at the UK’s first centre for synthetic biology. Prof Ellis is now leading the UK’s effort in the world’s largest synthetic biology project, the Synthetic Yeast Genome (Sc2.0) Project and is Associate Faculty for Synthetic Genomics at the Wellcome Trust Sanger Institute. He is not very good at either home baking or home brewing, but can at least understand DNA quite well.
Register via the link below.